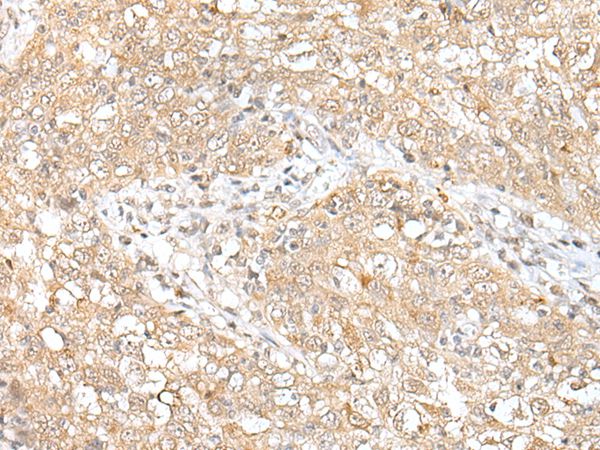

CHRNB2 Antibody (aa493-502)
LS-C16853
ApplicationsWestern Blot, ELISA, ImmunoCytoChemistry
Product group Antibodies
TargetCHRNB2
Overview
- SupplierLifeSpan BioSciences
- Product NameCHRNB2 Antibody (aa493-502)
- Delivery Days Customer23
- Application Supplier NoteSuitable for use in ELISA, Immunocytochemistry and Western Blot. Immunocytochemistry: 1:200. Stains fixed cells known to express the nicotinic beta 2 receptor using ABC techniques. Western Blot: 1:400. Using tissue homogenates to yield a single band at 60kD.. ELISA, ICC (1:200), WB (1:400) Suitable for use in ELISA, Immunocytochemistry and Western Blot. Immunocytochemistry: 1:200. Stains fixed cells known to express the nicotinic beta 2 receptor using ABC techniques. Western Blot: 1:400. Using tissue homogenates to yield a single band at 60kD.
- ApplicationsWestern Blot, ELISA, ImmunoCytoChemistry
- CertificationResearch Use Only
- ClonalityPolyclonal
- ConjugateUnconjugated
- Estimated Purity...
- Gene ID1141
- Target nameCHRNB2
- Target descriptioncholinergic receptor nicotinic beta 2 subunit
- Target synonymsacetylcholine receptor, nicotinic, beta 2 (neuronal); beta2 human neuronal nicotinic acetylcholine receptor; cholinergic receptor, nicotinic beta 2; cholinergic receptor, nicotinic, beta 2 (neuronal); cholinergic receptor, nicotinic, beta polypeptide 2 (neuronal); EFNL3; nAChRB2; neuronal acetylcholine receptor subunit beta-2; neuronal nicotinic acetylcholine receptor beta 2
- HostRabbit
- IsotypeIgG
- Storage Instruction-20°C,2°C to 8°C
- UNSPSC12352203